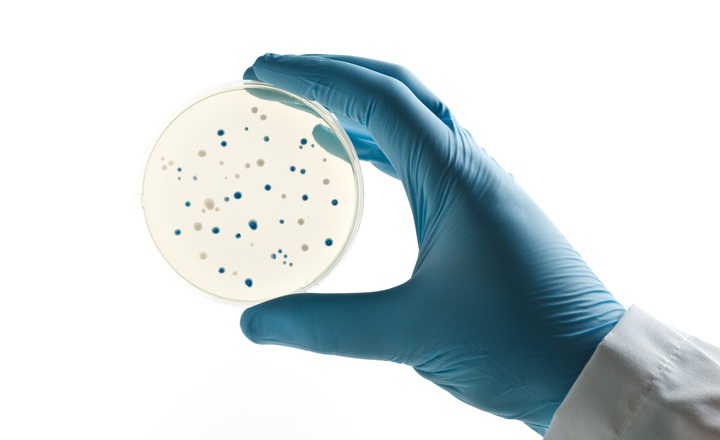
Improved recovery of ESBL-producing bacteria using chromogenic agar

Why This Matters:
- Extended-spectrum β-lactamase (ESBL)-producing Enterobacterales are associated with poor clinical outcomes and increased healthcare costs.
- Environmental reservoirs in sinks, drains, and high-touch surfaces within healthcare facilities may contribute to transmission, yet effective screening of these sites are infrequently deployed.
- Improving laboratory workflows for environmental surveillance of ESBL-producing organisms supports infection prevention and targeted interventions to interrupt spread in the healthcare setting.
Key Findings: Picton-Barlow et al. (2025) sampled environmental sites (sinks, toilets, shower drains, shower heads, and high-touch surfaces) across six healthcare facilities in the UK, and evaluated multiple culture-based methods to recover Extended-spectrum beta-lactamase (ESBL)-producing E. coli (ESBL-Ec) and K. pneumoniae (ESBL-Kp), including two swab types, two pre-enrichment broths, two incubation times, and four selective agars.1
- Extended pre-enrichment enhances recovery: Pre-enrichment for 18 hours significantly increased recovery of third-generation cephalosporin-resistant Gram-negative organisms compared with a 4-hour incubation.
- Selective agar choice affects yield and accuracy: CHROMagar ESBL and cefotaxime-supplemented Membrane Lactose Glucuronide Agar demonstrated the highest overall yield and detection accuracy for ESBL-Ec and ESBL-Kp recovery and species differentiation.
- Swab type has less impact: Foam versus polyester swabs did not strongly dictate ESBL recovery when optimal pre-enrichment and plating conditions were applied.
- Balancing detection and feasibility: The optimized workflow consisting of18-hour pre-enrichment in Buffered Peptone Water followed by plating on cefotaxime-supplemented selective medium balanced high detection efficacy with scalable cost and practical feasibility for routine surveillance.
Bigger Picture: This study addresses a critical surveillance need in healthcare environmental microbiology — namely, how to reliably recover ESBL-producing E. coli and K. pneumoniae from surfaces that could serve as reservoirs for resistant organisms. Standard environmental culture approaches have limited sensitivity; by integrating extended pre-enrichment and carefully chosen selective media, laboratories can substantially improve detection yield and accuracy. Such refined workflows enhance the ability of infection control programs to identify contamination hotspots, assess intervention impact, and reduce the risk of resistant pathogen transmission. Continued optimization and validation across diverse settings will further strengthen environmental AMR surveillance and inform evidence-based infection prevention strategies.
(Image Credit: iStock/ dra_schwartz)
References:
- Picton-Barlow et al. (2025). An Evaluation of Screening Methods for the Detection of Extended-Spectrum Beta-Lactamase-Producing Escherichia coli and Klebsiella pneumoniae in Environmental Samples from Healthcare Settings. Journal of Applied Microbiology.